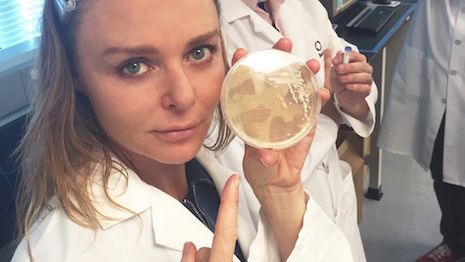

Kering-owned fashion label Stella McCartney has inked a partnership with a biotechnology company to advance and innovate the manufacturing of textiles.
Stella McCartney will work with San Francisco-based Bolt Threads to push fashion forward in regard to exploring alternative textiles and manufacturing techniques. Bolt Threads' approach aligns with Stella McCartney’s dedication to sustainability and eco-friendly fashions (see story) by creating only fibers based on proteins found in the natural world.
Luxury lab coats and all
Stella McCartney and Bolt Thread’s first collaborative project, in the continual pursuit for more sustainable materials, is a vegan spider silk made from yeast.
“This is something that I’ve been personally on a journey to find for much of my career and I just feel like there is finally a new opportunity to bring so many industries together and for them to all work as one for a better planet,” Ms. McCartney said in a statement. “It is a truly modern and mindful approach to fashion.”

Stella McCartney and Bolt Threads collaborated on a vegan spider silk created from yeast. Image credit: Bolt Threads
The first physical manifestation of Stella McCartney and Bolt Threads partnership will be featured at the upcoming “Items: Is Fashion Modern?” design exhibit at the Museum of Modern Art in New York.
Opening Oct. 1, the exhibit will explore the present, past, and also the future, of 111 pieces of apparel and accessories that have made an impact on the world in the 20th and 21st centuries.
Stella McCartney’s one-of-a-kind piece on view during the exhibit will be a golden-yellow shift dress designed using Bolt Threads’ signature protein-based yarn inspired by spider silk.

Stella McCartney's one-of-a-kind Bolt Thread shift dress will be on view during MoMA's Items: Is Fashion Modern Oct. 1 to Jan. 28, 2018. Image credit: Bolt Threads
In the future, Stella McCartney and Bolt Threads will continue its relationship to unveil new initiatives to set the standard for environmentally friendly luxury fabric.
{"ct":"9M+lABR+BqkfyyTHiRZQYEpmj\/+UZsoxtveB4g6pTs5vVrGU6YxuEvOqZSTI1ANe+JXY5frITidbE2ZpDpHhY2AbQQCHe1vWM4e4tr3FLKw1jcc2LVea+ts9MxBs55fNSkdtX\/cqG0qWDXfLnCqQkJDNA6wp87\/sIXnQagYD2cyWmHUKoyTreoDnYwlDO5YZ03fh+vLmHQLAl6a\/mi9x\/ZzVvL3rKdTTvAAJ+AYV7LgJq68EwYADl9kZd9sAoyu\/goyKmXZyZkec9TzUqBDUNTb7ej6iGfFNIXT17\/1OmGVC+l96C39nqvEMnZ8I\/XGXcT2lkkg1GOGWxTTbdOA44XEBcSmLHc4HcEXNNYPMeM\/\/18OUZ8lMUvRtaAU0Hcd+2bhxmRznfxf5cxGxyBRGspcYAcijZw64ofbIGcLxRA8xc7jMR6mT3uttR0yDejZQDaxUI+jPSF1RI4ULtLHF6jUW\/f8rQRJFa7RK1R\/ME\/6P\/C8BXVCJtSOkFCy0E2D2wjk2mHVz+\/t3Y\/db9b60c5yyhT2Axuyxm3DlYx6To498J8XS2Qo6oFGY9lx47VgtU\/icQWNN52wRAhqYlqfmr7NA0FZboGlrLnjnRDF+nFAu2SZvlY5nrv\/Uenles1\/MMroUtws9c+O032MIJZzAal\/U\/f1sgZKE2Jb53h\/yGLPgYrz2feX3OJ7oY1pARP5cBaGHpi9TuzpfLpYgPdf+tltOqYOygkKpl7D\/Ueicfz5ivM4xErIR7e4YRV3GP747FyR8umqqwD08oSJ8RH98YqvBoy6zvlZvl+uDQFQb8vNJs+jikCT8B+qvgMWewNLzZhlNw8CbD0Q34KvKVHwp736okmyK2u956VTAQmhvpWQvTCYKPZBvVVN5tG82K06YLov2jyd6loAOxtZDu3u8uaoAp0k3StlKPiPk\/B3J9TOAPahzAX1tF9pan9dEhlcZSqczZquk8WusxL5TzaA9An0hrGyWyYTP7C32A4DvWV2duPvG5A4psnR+uXZu\/ybROln8kvsmAnfJN7rZJ\/k5miqupeVkLuDBW7kvzL7RRbFZ2\/S5EEBk\/APAPNhV3oMixsS+b5CCl2NKv4jLCHBl+pZIMGh1Qvv0D5JqXfgwaZWMUXDPIVgM44JV42WffMy8D2MwItF66k5pfAeenQqmq6wgnUlbY9VfFAh81JKzYwiamtXjkMt\/3vXFrTISOrEpq3iT0MZ6Y0OHfx0zwg3ekAyePinIqbSosCltogJSOUEpHHiYeVXWDMDoUhUygQ\/1Vcr2gxDZ6WsHfDEG6Ml0zDjTLLzOTsqOGr50tfPfXcMaVFOdLb1sUP4tnBfOBSkGQts56pWhIXTtQHs5Otd4vb2ibAmp7lpjgD2V5p3KdTf+eTzTZHGwvDFcKDRvMU9PR6glIR01YD70Nw21iBIO4uTR30tY9HFV27t6NbCSVAbHMnAJU2+l16DzDEAfr3wM5EkHEp+2x9hU6fPBx29\/2uhLYoo8ZtZyqO1EWbD34dINs1nNx4rWj1+3IFAuNo+a42dqr30jLWNvlmqCYte7XdIS8KsjIuuJ3Y8qSZ9tHSMVIR3pxCcIUdV1Ax73HiSBdTBbPi5sKFMHWtK2sHFotf2rj2XJGy+VZfoRXOCIAXWhnFpaY0mTzKb+uVyHmgr+RtQTIkBOAZPGRQXRAdC6c30MTqbY\/sRT0\/NRPAc5EEFwv3VVsNthRMMNRwbuA4f0GtneqYUjx3MwvrjjIiW4zxUUuwf6h\/9esDpwW3RedHRNryxDoCaLKsLzfGQ1jzeIfglSwX0EKX+oYGiQ3B3luAdPWPae\/A+R6yvbti+CfV\/hyUTB0R\/P70FEtyLRovB1qP\/dSovjuywxo4lbihWXLl8FxtShyZuyV+WQjc1HTC6fKzTR6XhjcyRBVUsMqRJjbHy67qwJkFkaKrEAOfMW+Z9fzClPOFWlU7PLhBVwdLieyv8yC\/2vfqExIRnKcujTg2Sx423vmAPIDhhJeMjE1fcOlSF6welrQ6wnccrmIu8FaPGdkxh1f8AutKKH8\/u\/Z\/XmYvqEfsa5deMWU\/EBtoUhCSpkqThyj+BZzl2GlItsN0UJawQI\/Ti9SB4W1AT7eba3tIFMewpk5RmVQC0A7\/poFKikpjiIkFEdHkm2UIFpDTUM7Kd9uJ05Pe7xT\/Cl3QVYsYmXgbbN+NBwXe9GehZHeqNWoIwoXSRYsHJ9a\/uBMtDPXWQECmgNlGdtI7fp\/rqfhO95TD3rGWpbH91iQ+5RIU7Lt0UVYR0\/BSsJOB0IAWerI6xM5h4hVLtiHMqz33etSSAB2ezEpXG5CxyDg2MnMAga0k\/dMN\/PnToKFCMCg3PELNkDyLgE3tEHMDPfqBO2eynFWibTumtzx5Nf+uccCUF617JYxDN6EgshQfO2CVVF80rzE1HkA\/nfHVpiOJRbHrHIQlyVki6icmE+6AZ27KTVHK2C7uXmr3KxzJkbpweaZvCacouJ3Dtl158L7oxDnNe4+ZgXNPGuBSYYnUvLsmUzb41AG+rl8PTsKyYCxWiop\/sGEM2M8LrrFNwVJGbevn8Wx470O4k+HqZifn3qE3H5JVzgKzR2ZtK3i+mkvK98Apu48Cyx+FAB\/HbBB9S2FrgLjTDu3SJuWFcQddQMRr7cfmnrhTf0wp4XCknZ+kpWcjOwUREuWeLcyDk4kLsvsZAHinv3X4VupC4nja\/fs3US2umQjACxIF0jiyaEbGCxtJKHQbpy\/ERartQZ614IxlgOYHhX4OP7RehO+eh61phs6zpy1UcIsK++qKd9+OCPJ3QZVz9Iyk+nLQ4V3NuvjWzOAbwadibPCzUmgE2AW9KhOccChqE+LvB6nXicbO576Z92QZ0cCLCc9lloKLnPaxgR2jOm7AiMEkgWTWIDY3eyMN5x92TYKlmMUDskOsreuN0fdi1ELAPvw+pqDi1KhCPsfXT6ZbZJx1gvzCVyrbPGYQQ8vlRSAJw+aiVH3c6hsMPjkKVO2sTuL6lR8rpxSm2LmW\/czGFxNfxtiixNkgF7anUk8S4ktHWzypveMLAsN+c7PLQVv2n7zdmRwaZv\/qRaer5SDiNWCEgmwwKZyfn9aB+yI9bGTpia2UyoTFmMxJufhR5kSqCyBti+Z1cQcNsTm\/LEf570o54IjyGL1WgWSb\/\/rrpMFGu8PAlpAObNIeicysnmjLYWiiYZuVfAC42jwbt48W5wGlqSx8hRWLxTsOtKTrXmznLeiwAUkT+++a1YIMElQ72QphN5O3PZ+8R1WTz5H7DaLtqLmZTNolFNnbUEktrvO9TYCoF5olGZWsXxmB8ebLCL9VukeKHFxwlsKXwyWgnDmzsAVYAjJQHTsOYBHHtQS478vxCFeG\/6RSWUkqb8S1\/elssvxsIeqm\/4XgSeToFXKJ\/S1kfuGO2ZKVSI8UDz\/M\/R9neYfwNMAaJU2f2Z488gfWGoGOupv0hUSfnc7Hp3cqfHtYk4wtOvQNHtIFNaNlR8PA9XG0miGGI3cLwGLFyo6PCwIs0qVLTf30mDzLmC6w0sQvvRGRHrG+avjdabLbzo1TH5IRopEBUeZ7EpWY\/7DfdwXnJg+IoYLO0xhwWtTicyRqv1sinkle45VWfLyArpM2iLM7DHIwZp2qCg8fXXujrovnlGXk2eOiAKF\/bAgCpu\/bHUo9llvDNBQWnny9VKbCfcnupecmE9XXAc93IrdRU1YdxU+kkZcMcNHAsvjgUzu9eaLNuSIkbKoW0UrwFh3hDmoONwj9xIr1bG03aA0I\/vmeAus8wCWKmxpDnx3KgJ\/8ijsiY1yMPMF8osJ1NaO47F0AUfQqbL3PMn723+X0BehRmmWn6J6+M+u6p9Lu8xGP7dc2SsnvUn2oo6m5z+20VloD6CSE3rMmfVozvg5HZ95uekl1Ybw7Vqr1TLU1ai06o9+VNNIXNI7APBJdIHZv543+tdQc0QRCwqbhILaUnJAr1ANzEnnbCYNw0qupINLpy91To860KFIkMXW6v4q1vUVR0DzP0mHn1ufvSO4ATDGYiRzg\/CGO8wo4oguX9chFqT202Q1fWvsbBEbfaPMy8\/YorG6E13XiVvvHXT5NXxdG\/drN\/SUHz8vIYd\/o0CtKsQxSnSTu0qF3rf5HrT\/5ZhKK8pi4\/xdrB1F5u9\/NmnlD\/aWqmIu7B0O2DqugNmLRXOjkG373I2zj6gn7rWJ2k=","iv":"5d57a8fc91ad307cfa211198e74d728e","s":"852e9f3c3ab5b103"}
Stella McCartney made a visit to Bolt Threads' San Francisco lab. Image credit: Stella McCartney
Stella McCartney made a visit to Bolt Threads' San Francisco lab. Image credit: Stella McCartney